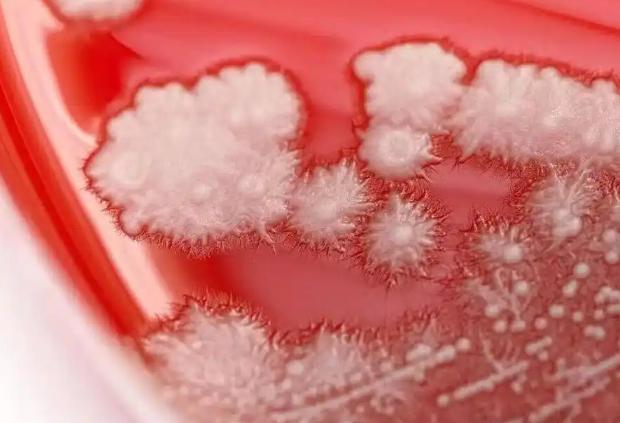

“悲剧还是发生了!”近日,浙江宁波,一男子感觉喉咙有些痛,以为是降温感冒了,就买了些抗生素服用,结果吃了一个多月的药,喉咙还是不舒服,去医院检查后,被确诊为真菌性咽喉炎,嗓子里竟全是“雪花”!网友:这是发霉了? 最近几天降温非常严重,不少人因为没有及时增加衣物,导致了感冒发烧,大家平时一定要注意,一旦生了病就要及时就医,千万不要自行配药服用。 据媒体11月3日的报道,张先生是一名销售人员,平日里常常在外奔波,需要和不同的人打交道,嗓子发炎那是常有的事。 前不久,气温变化的有些厉害,张先生又感觉嗓子有些不舒服,他以为这是着凉感冒了,所以没有太在意,自己去药店买了些头孢和阿奇。 吃了一段时间后,张先生却没有丝毫好转,这令他有些纳闷,又过了一段时间,张先生感觉喉咙的情况变得更加糟糕,于是前往医院检查。 医生检查后,发现张先生的咽后壁上竟有一层“雪花”!这些都是白色念珠菌,他这是真菌性肺炎。原来,张先生胡乱吃药,再加上本身抵抗力差,结果被真菌趁虚而入。 好在经过医生的针对性治疗,张先生已经恢复了健康。 大家千万不要病急乱投医,有些病症看似一样,但却是不同的病因,因此不能一概而论,当身体出现不适时,最好还是立即就医检查,这样才能避免意外。 信息来源:《男子喉咙痛一月不见好,竟发现嗓子里全是“雪花”!医生:这事可别乱做》潇湘名医